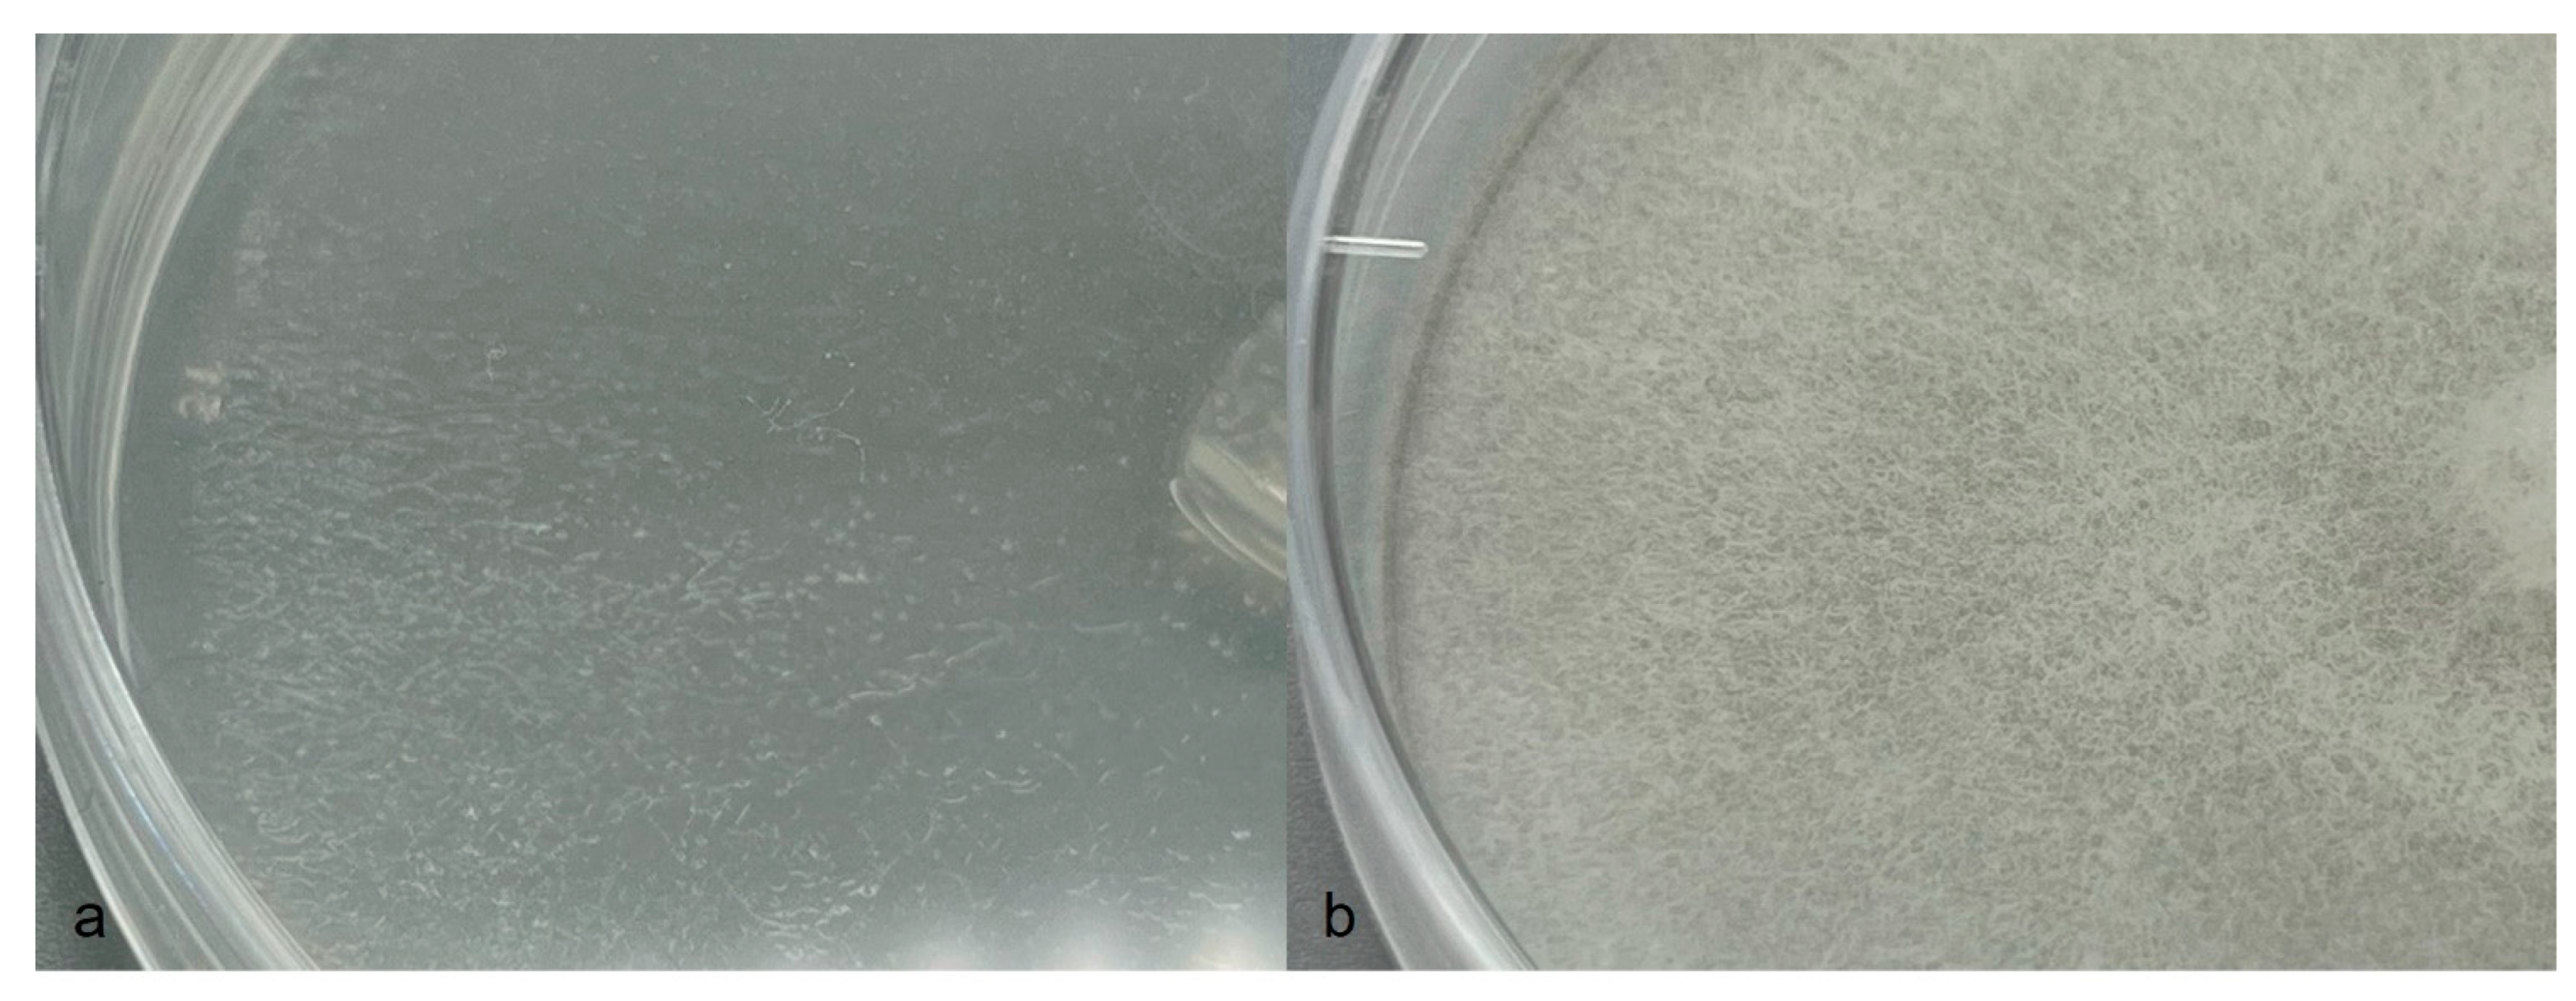

Aphanomyces macrosporus sp. nov. Causing Root Rot in Barley and Some Other Plants
Abstract
:1. Introduction
2. Materials and Methods
2.1. Field Surveys and Pathogen Isolation
2.2. Pathogenicity
2.3. Morphology
2.4. Temperature Response
2.5. Molecular Characterisation
| Scientific Name | GenBank Accession Number | Host | Geographical Origin | Reference |
|---|---|---|---|---|
| A. macrosporus B8 | OQ972001 | Hordeum vulgare | Sweden | This study |
| A. macrosporus B9 | OQ972002 | Hordeum vulgare | Sweden | This study |
| A. macrosporus B10 | OQ972003 | Hordeum vulgare | Sweden | This study |
| A. macrosporus B11 | OQ972004 | Hordeum vulgare | Denmark | This study |
| A. macrosporus B12 | OQ972005 | Hordeum vulgare | Sweden | This study |
| A. macrosporus B13 | OQ972006 | Hordeum vulgare | Sweden | This study |
| A. macrosporus B14 | OQ972007 | Hordeum vulgare | Sweden | This study |
| A. macrosporus B15 | OQ972008 | Hordeum vulgare | Sweden | This study |
| A. macrosporus B17 | OQ972009 | Hordeum vulgare | Sweden | This study |
| A. macrosporus B18 | OQ980615 | Hordeum vulgare | Sweden | This study |
| A. macrosporus B19 | OQ972010 | Hordeum vulgare | Sweden | This study |
| A. macrosporus B20 | OQ980616 | Hordeum vulgare | Sweden | This study |
| A. macrosporus | AY353921 | Phaseolus vulgaris | Sweden | [12] |
| A. cladogamus | AY353913 | Medicago sativa | Sweden | [12] |
| A. cladogamus | AY353918 | Spinacia oleracea | Sweden | [12] |
| A. trifolii | GQ267548 | Trifolium subterraneum | Australia | [20] |
| A. trifolii | GQ267549 | Trifolium subterraneum | Australia | [20] |
| A. cochlioides | FM999224 | Beta vulgaris | Sweden | [15] |
| A. cochlioides | AY353911 | Beta vulgaris | Sweden | [12] |
| A. raphani | MK513783 | Fresh water | Brazil | [21] |
| A. euteiches | AY353901 | Pisum sativum | Sweden | [12] |
| A. euteiches | AY353902 | Pisum sativum | USA | [12] |
| A. euteiches | AY353906 | Vicia arvense | Sweden | [12] |
| A. euteiches | AY353907 | Medicago sativa | USA | [12] |
| A. euteiches | AY353908 | Medicago sativa | USA | [12] |
| A. euteiches | AY353909 | Phaseolus vulgaris | USA | [12] |
| A. euteiches f. sp. phaseoli | AY353910 | Phaseolus vulgaris | USA | [12] |
| A. iridis | HQ643121 | Iris hollandica | Japan | [22] |
| A. invadans | FM999229 | Brevoortia tyrannus | USA | [15] |
| A. invadans | FM999231 | Brevoortia tyrannus | USA | [15] |
| Saprolegnia diclina | KM061644 | Water | Falkland Islands | NCBI Genbank |
| Saprolegnia parasitica | AY455776 | Salmo trutta | Outgroup | NCBI Genbank |
3. Results
3.1. Pathogen Isolation, Disease Symptoms, and Pathogenicity
3.2. Temperature Limits and Optima
3.3. Phylogenetic Analysis
3.4. Taxonomy
4. Discussion
Author Contributions
Funding
Data Availability Statement
Acknowledgments
Conflicts of Interest
References
- Scott, W.W. A monograph of the genus Aphanomyces. Va. Agric. Exp. Stn. Tech. Bull. 1961, 151, 1–95. [Google Scholar]
- Johnson, T.W., Jr.; Seymour, R.L.; Padgett, D.E. Biology and Systematics of the Saprolegniaceae; University of North Carolina at Wilmington, Dept. of Biological Sciences: Wilmington, NC, USA, 2002. [Google Scholar]
- Chan, M.K.Y.; Close, R.C. Aphanomyces root rot of peas 2. Some pasture legumes and weeds as alternative hosts for Aphanomyces euteiches. N. Z. J. Agric. Res. 1987, 30, 219–223. [Google Scholar] [CrossRef]
- Kälin, C.; Berlin, A.; Kolodinska Brantestam, A.; Dubey, M.; Arvidsson, A.K.; Riesinger, P.; Elfstrand, M.; Karlsson, M. Genetic diversity of the pea root pathogen Aphanomyces euteiches in Europe. Plant Pathol. 2022, 71, 1570–1578. [Google Scholar] [CrossRef]
- Larsson, M.; Olofsson, J. Prevalence and pathogenicity of spinach root pathogens of the genera Aphanomyces, Phytophthora, Fusarium, Cylindrocarpon, and Rhizoctonia in Sweden. Plant Pathol. 1994, 43, 251–260. [Google Scholar] [CrossRef]
- Olsson, Å.; Persson, L.; Olsson, S. Variations in soil characteristics affecting the occurrence of Aphanomyces root rot of sugar beet—Risk evaluation and disease control. Soil Biol. Biochem. 2011, 43, 316–323. [Google Scholar] [CrossRef]
- Papavizas, G.C.; Ayers, W.A. Aphanomyces Species and Their Root Diseases in Pea and Sugarbeet. U.S. Dep. Agric. Agric. Res. Serv. Tech. Bull. 1974, 1485, 158. [Google Scholar]
- Sherwood, R.T.; Hagedorn, D.J. Determining Common Root Rot Potential of Pea Fields. Wis. Exp. Stn. Bull. 1958, 531, 1–11. [Google Scholar]
- Windels, C.E. Aphanomyces Root Rot on Sugar Beet. Plant Health Prog. 2000, 1, 1–6. [Google Scholar] [CrossRef]
- Zitnick-Anderson, K.; Porter, L.D.; Hanson, L.E.; Pasche, J.S. Laboratory, Greenhouse, and Field Handling of Aphanomyces euteiches on Pea (Pisum sativum). Plant Health Prog. 2021, 22, 392–403. [Google Scholar] [CrossRef]
- Larsson, M. Pathogenicity, morphology and isozyme variability among isolates of Aphanomyces spp. from weeds and various crop plants. Mycol. Res. 1994, 98, 231–240. [Google Scholar] [CrossRef]
- Levenfors, J.P.; Fatehi, J. Molecular characterization of Aphanomyces species associated with legumes. Mycol. Res. 2004, 108, 682–689. [Google Scholar] [CrossRef] [PubMed]
- Wenham, H.T. Black root disease of radishes caused by Aphanomyces raphani Kendr. New Zealand J. Agric. Res. 1960, 3, 179–184. [Google Scholar] [CrossRef]
- Swofford, D.L. PAUP* Phylogenetic Analysis Using Parsimony * (and Other Methods), version 4.0; Sinauer Associates: Sunderland, MA, USA, 2002. [Google Scholar]
- Diéguez-Uribeondo, J.; García, M.A.; Cerenius, L.; Kozubíková, E.; Ballesteros, I.; Windels, C.; Weiland, J.; Kator, H.; Söderhäll, K.; Martín, M.P. Phylogenetic relationships among plant and animal parasites, and saprotrophs in Aphanomyces (Oomycetes). Fungal Genet. Biol. 2009, 46, 365–376. [Google Scholar] [CrossRef] [PubMed]
- McCarthy, C.G.; Fitzpatrick, D.A. Phylogenomic Reconstruction of the Oomycete Phylogeny Derived from 37 Genomes. MSphere 2017, 2, 10–128. [Google Scholar] [CrossRef] [PubMed]
- Nylander, J.A.A. MrModeltest Version 2. Program Distributed by the Author; Evolutionary Biology Centre, Uppsala University: Uppsala, Sweden, 2004. [Google Scholar]
- Tavaré, S. Some probabilistic and statistical problems in the analysis of DNA sequences. Am. Math. Soc. Lect. Math. Life Sci. 1986, 17, 57–86. [Google Scholar]
- Huelsenbeck, J.P.; Ronquist, F. MRBAYES: Bayesian inference of phylogenetic trees. Bioinformatics 2001, 17, 754–755. [Google Scholar] [CrossRef] [PubMed]
- O’Rourke, T.A.; Ryan, M.H.; Li, H.; Ma, X.; Sivasithamparam, K.; Fatehi, J.; Barbetti, M.J. Taxonomic and pathogenic characteristics of a new species Aphanomyces trifolii causing root rot of subterranean clover (Trifolium subterraneum) in Western Australia. Crop Pasture Sci. 2010, 61, 708–720. [Google Scholar] [CrossRef]
- Pires-Zottarelli, C.L.A.; Colombo, D.R.S.; Da Paixão, S.C.O.; Ventura, P.O.; Boro, M.C.; De Jesus, A.L. Aphanomyces brasiliensis sp. nov. (Verrucalvaceae, Saprolegniales): A new species from Brazilian Atlantic Rainforest areas. Phytotaxa 2019, 415, 208–216. [Google Scholar] [CrossRef]
- Robideau, G.P.; De Cock, A.W.A.M.; Coffey, M.D.; Voglmayr, H.; Brouwer, H.; Bala, K.; Chitty, D.W.; Désaulniers, N.; Eggertson, Q.A.; Gachon, C.M.M.; et al. DNA barcoding of oomycetes with cytochrome c oxidase subunit I and internal transcribed spacer. Mol. Ecol. Resour. 2011, 11, 1002–1011. [Google Scholar] [CrossRef]
- Brown, M.; Jayaweera, D.P.; Hunt, A.; Woodhall, J.W.; Ray, R.V. Yield losses and control by sedaxane and fludioxonil of soilborne Rhizoctonia, Microdochium, and Fusarium species in winter wheat. Plant Dis. 2021, 105, 2521–2530. [Google Scholar] [CrossRef]
- Ingram, D.M.; Cook, R.J. Pathogenicity of four Pythium species to wheat, barley, peas and lentils. Plant Pathol. 1990, 39, 110–117. [Google Scholar] [CrossRef]
- Drechsler, C. The beet water mold and several related root parasites. J. Agric. Res. 1929, 38, 309–361. [Google Scholar]
- Hall, G. Aphanomyces raphani. CMI descriptions of pathogenic fungi and bacteria. No. 973. Mycopathologia 1989, 106, 187–188. [Google Scholar] [CrossRef]
- Levenfors, J.P.; Wikström, M.; Persson, L.; Gerhardson, B. Pathogenicity of Aphanomyces spp. from different leguminous crops in Sweden. Eur. J. Plant Pathol. 2003, 109, 535–543. [Google Scholar] [CrossRef]
- Jordbruksverket. Yield of Agricultural Plants in Sweden, Data Up to 2022. 2023. Available online: https://jordbruksverket.se/om-jordbruksverket/jordbruksverkets-officiella-statistik/statistikdatabasen (accessed on 1 May 2023).

| Oospore Ø | Oogonium Ø | ||||||
|---|---|---|---|---|---|---|---|
| Isolate | Host | Mean | SEM 1 | Range | Mean | SEM | Range |
| A. macrosporus B8 | Barley | 29 | 0.9 | 20–36 | 42 | 1.8 | 27–57 |
| A. macrosporus B9 | Barley | 27 | 1.3 | 17–40 | 38 | 2.1 | 24–60 |
| A. macrosporus B10 | Barley | 27 | 0.9 | 18–35 | 37 | 1.6 | 25–55 |
| A. macrosporus B11 | Barley | 23 | 0.6 | 19–31 | 30 | 1 | 23–42 |
| A. macrosporus B12 | Barley | 27 | 0.8 | 21–32 | 37 | 1.1 | 29–47 |
| A. macrosporus B13 | Barley | 25 | 0.5 | 21–30 | 34 | 1 | 27–47 |
| A. macrosporus B14 | Barley | 26 | 0.5 | 22–30 | 34 | 0.9 | 29–45 |
| A. macrosporus B15 | Barley | 28 | 1.1 | 18–38 | 37 | 1.4 | 28–54 |
| A. macrosporus B17 | Barley | 24 | 0.6 | 19–30 | 33 | 1 | 25–42 |
| A. macrosporus B19 | Barley | 21 | 0.6 | 15–24 | 30 | 1 | 23–41 |
| Aphanomyces sp. 3 BC 2 | Barley | 20 | 0.5 | 15–25 | 31 | 0.7 | 25–42 |
| Aphanomyces sp. 3 BD 2 | Barley | 26 | 1.2 | 21–30 | 35 | 1.5 | 27–48 |
| Aphanomyces sp. 3 C 2 | Barley | 21 | 1.3 | 16–24 | 35 | 1.5 | 26–47 |
| Aphanomyces sp. 3 D 2 | Barley | 26 | 0.7 | 21–31 | 36 | 1 | 26–52 |
| Aphanomyces sp. 3 AA 2 | Barley | 22 | 0.7 | 18–30 | 30 | 0.6 | 23–42 |
| Aphanomyces sp. 3 BA 2 | Spinach | 26 | 1.2 | 18–32 | 35 | 1.5 | 27–54 |
| Aphanomyces sp. 3 T 2 | Spinach | 25 | 0.8 | 21–30 | 37 | 1.1 | 28–54 |
Disclaimer/Publisher’s Note: The statements, opinions and data contained in all publications are solely those of the individual author(s) and contributor(s) and not of MDPI and/or the editor(s). MDPI and/or the editor(s) disclaim responsibility for any injury to people or property resulting from any ideas, methods, instructions or products referred to in the content. |
© 2023 by the authors. Licensee MDPI, Basel, Switzerland. This article is an open access article distributed under the terms and conditions of the Creative Commons Attribution (CC BY) license (https://creativecommons.org/licenses/by/4.0/).
Share and Cite
Wikström, M.; Persson, L.; Fatehi, J. Aphanomyces macrosporus sp. nov. Causing Root Rot in Barley and Some Other Plants. J. Fungi 2023, 9, 1144. https://doi.org/10.3390/jof9121144
Wikström M, Persson L, Fatehi J. Aphanomyces macrosporus sp. nov. Causing Root Rot in Barley and Some Other Plants. Journal of Fungi. 2023; 9(12):1144. https://doi.org/10.3390/jof9121144
Chicago/Turabian StyleWikström, Mariann, Lars Persson, and Jamshid Fatehi. 2023. "Aphanomyces macrosporus sp. nov. Causing Root Rot in Barley and Some Other Plants" Journal of Fungi 9, no. 12: 1144. https://doi.org/10.3390/jof9121144
APA StyleWikström, M., Persson, L., & Fatehi, J. (2023). Aphanomyces macrosporus sp. nov. Causing Root Rot in Barley and Some Other Plants. Journal of Fungi, 9(12), 1144. https://doi.org/10.3390/jof9121144

